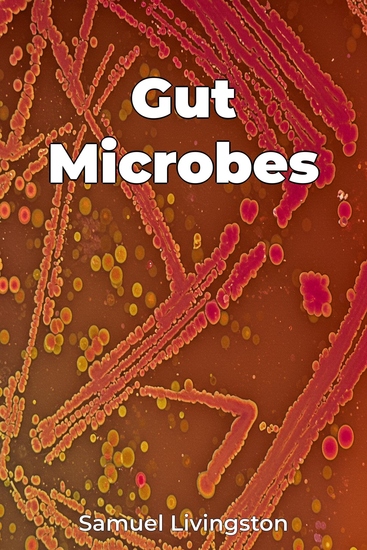

Gut Microbes
Samuel Livingston
Traducteur A AI
Maison d'édition: Publifye
Synopsis
Trillions of bacteria living within us profoundly impact our health, making the gut microbiome a key area of study in Health and Fitness. Gut Microbes explores this complex ecosystem, focusing on its roles in digestion and immunity. Disruptions in this delicate balance have been linked to conditions like Irritable Bowel Syndrome and autoimmune diseases, highlighting the importance of understanding and nurturing our gut microbiota. The book uses scientific research to show how diet and probiotics can modulate the microbiome to promote health. The book begins with basic microbiology, then systematically examines the gut microbiome's composition and function. Subsequent chapters delve into its specific roles in digestion, nutrient absorption, and immune system regulation. Highlighting the dynamic interplay between diet, gut microbes, and immunity, it moves beyond simple good vs. bad bacteria narratives. The gut-brain axis, a connection between gut health and mental well-being, is explored in depth within the book. Gut Microbes offers practical advice, empowering readers to improve their gut health through dietary modifications like increasing fiber intake and incorporating fermented foods. It also addresses controversies and ongoing debates in the field, presenting a balanced view of the evidence. By focusing on the relationship between the gut microbiome and human health, with an emphasis on digestion and immunity, this book provides a comprehensive and evidence-based understanding of this fascinating area.














